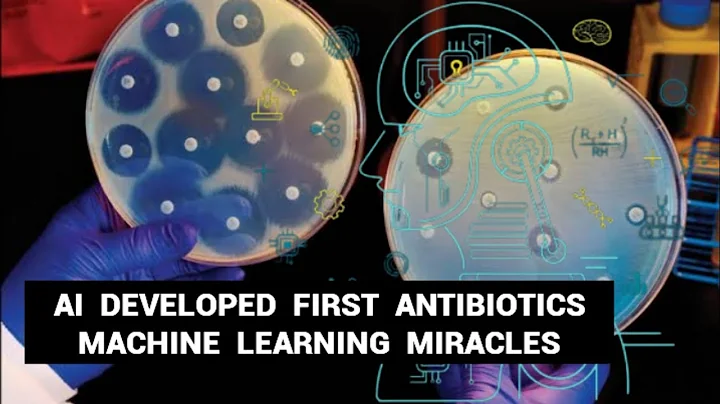
New superbug killing antibiotic discovered using AI

External Source
Ancient Microbes Vs. Superbugs: Ai Discovers Groundbreaking New Antibiotics
Synopsis
What if Earth's oldest microbes could help us defeat antibiotic resistance? In this video, discover how scientists from the University ...
Download Options
Choose a download method below. All links open in new tabs.
| Service | Features | Action |
|---|---|---|
| SaveFrom |
MP4 & MP3 • HD Quality • Browser Extension Available
|
Download |
Security Notice: These are third-party services. We recommend using antivirus software and being cautious of pop-up ads.